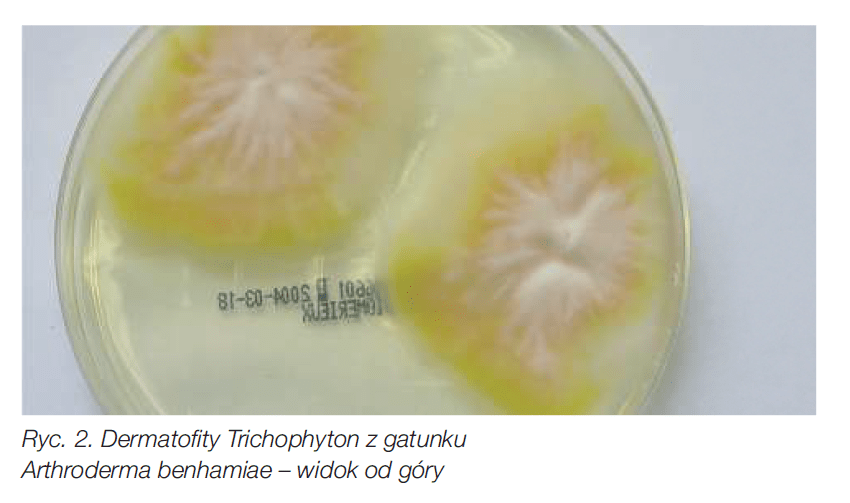
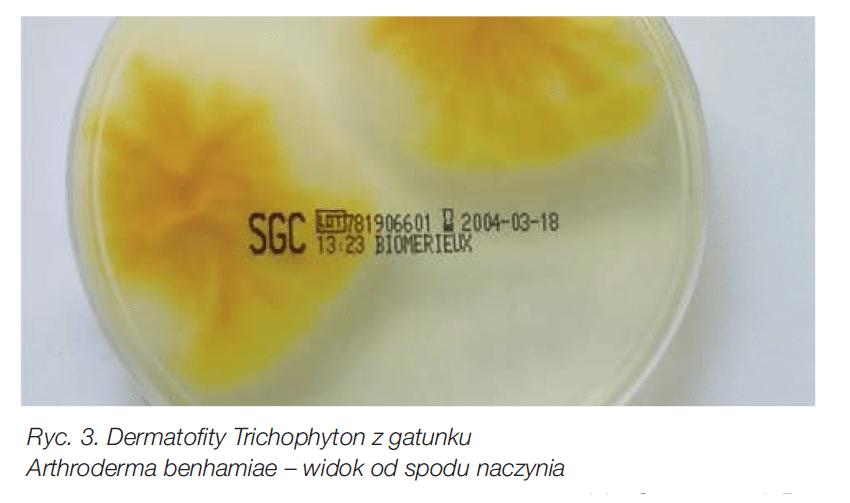
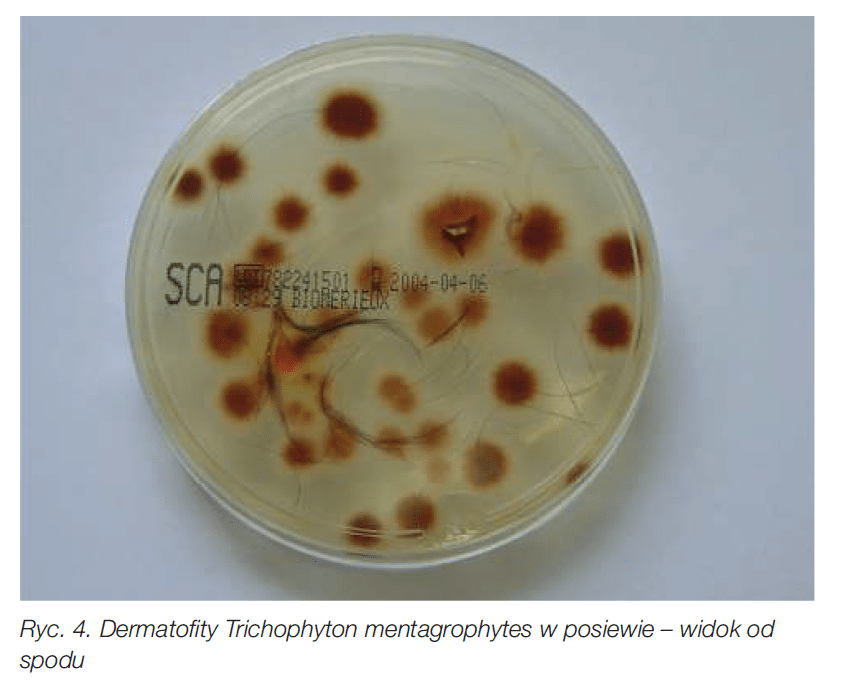
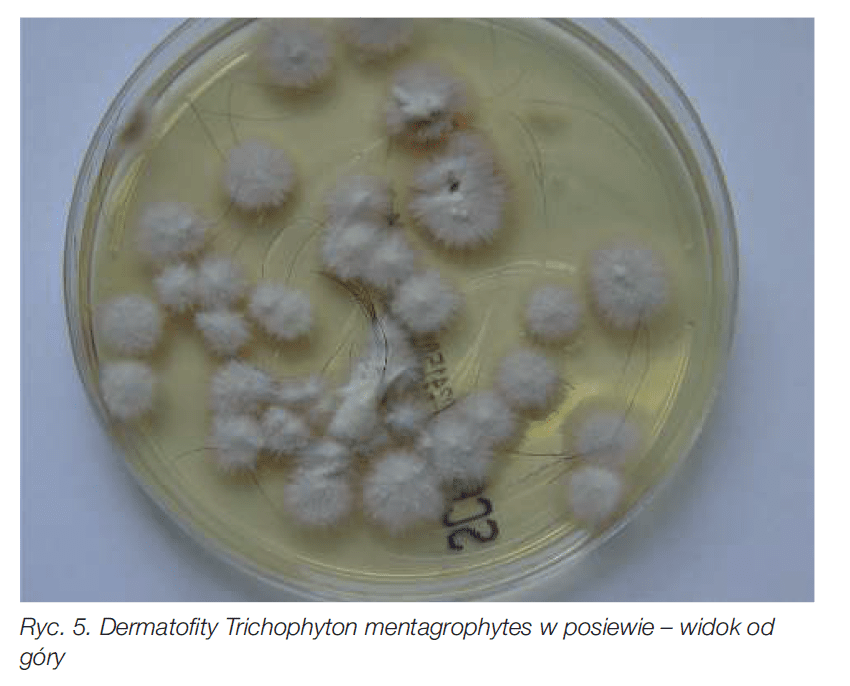

Wstęp
Dermatofity są grzybami niedoskonałymi i w stadium teleomorficznym zaliczane są do królestwa grzybów właściwych (Eumycota), gromady workowców (Ascomycota), podgromady Euascomycota, rzędu Onygenales, rodziny Arthrodermataceae i gatunku Arthroderma. Posiadają one rzadką zdolność rozkładania keratyny przy pomocy enzymów i mogą zasiedlać skórę, sierść i pazury. Mianem dermatofitoz określa się wszystkie zakażenia wywoływane przez grzyby z gatunków Epidermophyton, Microsporum oraz Trichophyton.
Klasyfikacja
Z taksonomicznego punktu widzenia grzyby skórne od ok. 80 lat dzieli się na trzy anamorficzne rodzaje:
- Microsporum,
- Epidermophyton,
- Trichophyton.
Grzyby z rodzaju Epidermophyton, który obejmuje zaledwie jeden gatunek, tj. Epidermophyton floccosum, występują wyłącznie u ludzi, niektóre grzyby z rodzajów Trichophyton i Microsporum mają charakter typowo zoonotyczny.
Różnicowanie wykonuje się makroskopowo w oparciu o wzrost oraz mikroskopowo na podstawie kształtu strzępek, ułożenia mikrokonidiów i kształtu makrokonidiów.
Dzięki możliwościom, jakie niesie ze sobą biologia molekularna, dokonano sekwencjonowania DNA grzyba, w wyniku czego fenotypowe cechy morfologiczne przestały odgrywać główną rolę, a klasyfikacja odbywa się obecnie w oparciu o ocenę postaci teleomorficznej.
Tym samym w obrębie rodzaju Arthroderma wyróżnia się:

W przypadku innych gatunków Trichophyton (m.in. Trichophyton verrucosum) nie są jak dotąd znane stadia teleomorficzne.
Zmiany w zachowaniu dermatofitów
Zoonotyczne dermatofitozy u małych gryzoni do tej pory wywoływane były prawie wyłącznie przez zoofilne szczepy Trichophyton mentagrophytes (obecnie Trichophyton interdigitale u ludzi).
Jednak od pewnego czasu obserwuje się diametralną zmianę w zachowaniu dermatofitów hodowanych na podłożach (podłoże Sabourauda z gentamycyną i chloramfenikolem hamującymi wzrost towarzyszącej flory bakteryjnej oraz podłoże Sabourauda z gentamycyną, chloramfenikolem i aktidionem hamującymi wzrost pleśni). W posiewie Trichophyton mentagrophytes charakteryzował się makroskopowo powierzchnią przypominająca wyglądem puder oraz brązowym kolorem na odwrocie. Od kilku lat notuje się jednak coraz częstsze przypadki pozytywnych posiewów z materiału pochodzącego od świnek morskich i królików, które na odwrocie mają kolor cytrynowy i których powierzchnia odznacza się lekkim rozchodzącym się promieniście pofalowaniem oraz niewielką ilością plechy. W ocenie makroskopowej ich morfologia przypomina raczej szczepy Microsporum canis, natomiast mikroskopowo mają one postać Trichophyton mentagrophytes.
Dopiero najnowsze metody z zakresu biologii molekularnej (m.in. sekwencjonowanie regionu TS kwasu DNA oraz MALDI TOF) umożliwiają jednoznaczne zaklasyfikowanie wykrytych grzybów do gatunku Arthroderma benhamiae.
Występowanie
Pierwsze zakażenia dermatofitami Trichophyton z gatunku Arthroderma benhamiae u ludzi opisywane były w Japonii już w roku 2002, natomiast w Niemczech były one stosunkowo rzadko przyczyną grzybic skóry. Jest to prawdopodobnie spowodowane nieprawidłową identyfikacją grzybów uzyskiwanych w posiewie.
W Niemczech, podobnie jak w Japonii, wektorem, a tym samym źródłem zakażenia były w większości małe gryzonie, głównie świnki morskie. Potencjalne źródło infekcji stanowią jednak również inne gryzonie, np. chomiki i szczury.
U człowieka – w przeciwieństwie do antropofi lnych grzybów skórnych – szczepy Trichophyton z gatunku Arthroderma benhamiae wywołują często wysoko zapalne zakażenia skóry. Prawdopodobnie jest to uwarunkowane obecnością prozapalanych cytokin, chemokin i cytokin immunomodulacyjnych, które w przypadku zakażenia Arthroderma benhamiae uwalniane są przez keratynocyty.
Diagnostyka w kierunku obecności dermatofitów Trichophyton z gatunku Arthroderma benhamiae
Lampa Wooda: przy wyniku negatywnym pod mikroskopem we wnętrzu zakażonego włosa widoczne są charakterystyczne zarodniki:

Na podłożu Sabourauda z glukozą dermatofi ty Trichophyton tworzą płaskie, jaskrawe kolonie z powietrzną grzybnią w kolorze beżowym lub żółtym oraz o intensywnie żółtym kolorze od spodu.

W niektórych posiewach otrzymuje się postać typową dla Trichophyton mentagrophytes o charakterystycznej powierzchni przypominającej puder, przy czym spód posiewu jest najczęściej jaskrawo żółty.

Na różnicowanie pomiędzy Trichophyton mentagrophytes i szczepami Trichophyton z gatunku Arthroderma benhamiae pozwalają z reguły wskazane powyżej różnice morfologiczne.
W niektórych przypadkach konieczne jest jednak różnicowanie metodą PCR lub MALDI TOF.
Leczenie
Do miejscowej terapii zakażenia i w celu redukcji liczby zarodników nadaje się każdy lek przeciwgrzybiczy wykazujący skuteczność przeciwko dermatofi tom, np. enilconazol. W leczeniu systemowym stosuje się dopuszczone do obrotu preparaty zawierające itrakonazol lub ketokonazol. Zgodnie z aktualnym stanem wiedzy szczepienie z użyciem szczepionki dopuszczonej do stosowania u psów i kotów, która nie zawiera jednak obu opisanych wyżej gatunków Arthroderma benhamiae, może wspomagać leczenie, lecz nie jest w stanie zapobiec nowemu zakażeniu.



